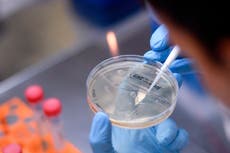

Primera vacuna contra el coronavirus de dosis única llega a la etapa final del ensayo en Estados Unidos
Johnson & Johnson está comenzando la etapa final de un gran estudio para tratar de probar si una vacuna COVID-19 de dosis única puede proteger contra el virus.
Johnson & Johnson está comenzando la etapa final de un gran estudio para intentar probar si una vacuna COVID-19 de dosis única puede proteger contra el virus
El estudio que comienza el miércoles será uno de los estudios contra el coronavirus más grandes del mundo hasta el momento, probando la vacuna en 60.000 voluntarios en los Estados Unidos, Sudáfrica, Argentina, Brasil, Chile, Colombia, México y Perú.
Un puñado de otras vacunas en los Estados Unidos, incluidas las inyecciones realizadas por Moderna Inc. y Pfizer Inc., y otras en otros países ya se encuentran en la etapa final de prueba. Hay muchas esperanzas de que las respuestas sobre al menos un candidato que se está probando en los Estados Unidos puedan llegar a fin de año, tal vez antes.
Los funcionarios de salud de Estados Unidos insisten en que en la carrera por una vacuna no debería haber atajos.
"Queremos hacer todo lo que podamos sin sacrificar la seguridad o la eficacia, no vamos a hacer eso, para asegurarnos de que terminemos con vacunas que salvarán vidas", dijo el Dr. Francis Collins, director de los Institutos Nacionales. de Salud, dijo a los periodistas.
Pero muchos especialistas en vacunas cuestionan si la Administración de Alimentos y Medicamentos se apegará a ese objetivo bajo la intensa presión de la administración Trump. El presidente Donald Trump ha presentado constantemente un cronograma más rápido para una nueva vacuna de lo que los expertos dicen que es adecuado para probar completamente a los candidatos.
Mientras tanto, la prueba de otra vacuna experimental, fabricada por AstraZeneca, permanece en suspenso en Estados Unidos, los funcionarios examinan una cuestión de seguridad, a pesar de que los estudios se han reanudado en otros países.
A principios de esta semana, el vicepresidente Mike Pence instó a los gobernadores estatales a "hacer su parte para generar confianza pública en que será una vacuna segura y eficaz".
Y el Dr. Anthony Fauci, el principal experto en enfermedades infecciosas de Estados Unidos agregó en la llamada a los gobernadores que confía en "un proceso probado y verdadero" que tiene controles y equilibrios integrados, incluida una junta independiente que evalúa el progreso de cada ensayo de vacuna, así como "la integridad de la FDA".
Estaba previsto que los senadores interrogaran al comisionado de la FDA Stephen Hahn, a Fauci y a otros funcionarios de la administración el miércoles más tarde sobre la respuesta a la pandemia.
Incluso si la FDA permitiera el uso de emergencia de una vacuna para fin de año, los suministros serían limitados y se entregarían primero a grupos vulnerables como los trabajadores de la salud. Es poco probable que la mayoría de los estadounidenses reciba una vacuna hasta el próximo año.
Los Centros para el Control y la Prevención de Enfermedades quieren que los estados se preparen ahora para implementar las vacunas, lo que presentará enormes desafíos logísticos. El miércoles, los CDC estaban listos para anunciar la distribución de $200 millones de dólares en fondos aprobados por el Congreso para ayudar a comenzar a establecer operaciones.
El secretario de Salud y Servicios Humanos, Alex Azar, dijo que la campaña de la vacuna COVID-19 se basará en la cooperación de larga data entre el gobierno federal y los estados en materia de inmunizaciones.
La vacuna de J&J está fabricada con una tecnología ligeramente diferente a la de otras en las últimas etapas de prueba, siguiendo el modelo de una vacuna contra el ébola que creó la empresa. A diferencia de las otras tres vacunas que comenzaron las pruebas de etapa tardía en los Estados Unidos, solo requiere una inyección, no dos. A pesar de un inicio de pruebas más tardío que algunos de sus competidores, el Dr. Paul Stoffels, director científico de J&J, dijo a los periodistas que el estudio era lo suficientemente grande como para dar respuestas posiblemente a principios del próximo año.

Bookmark popover
Removed from bookmarks